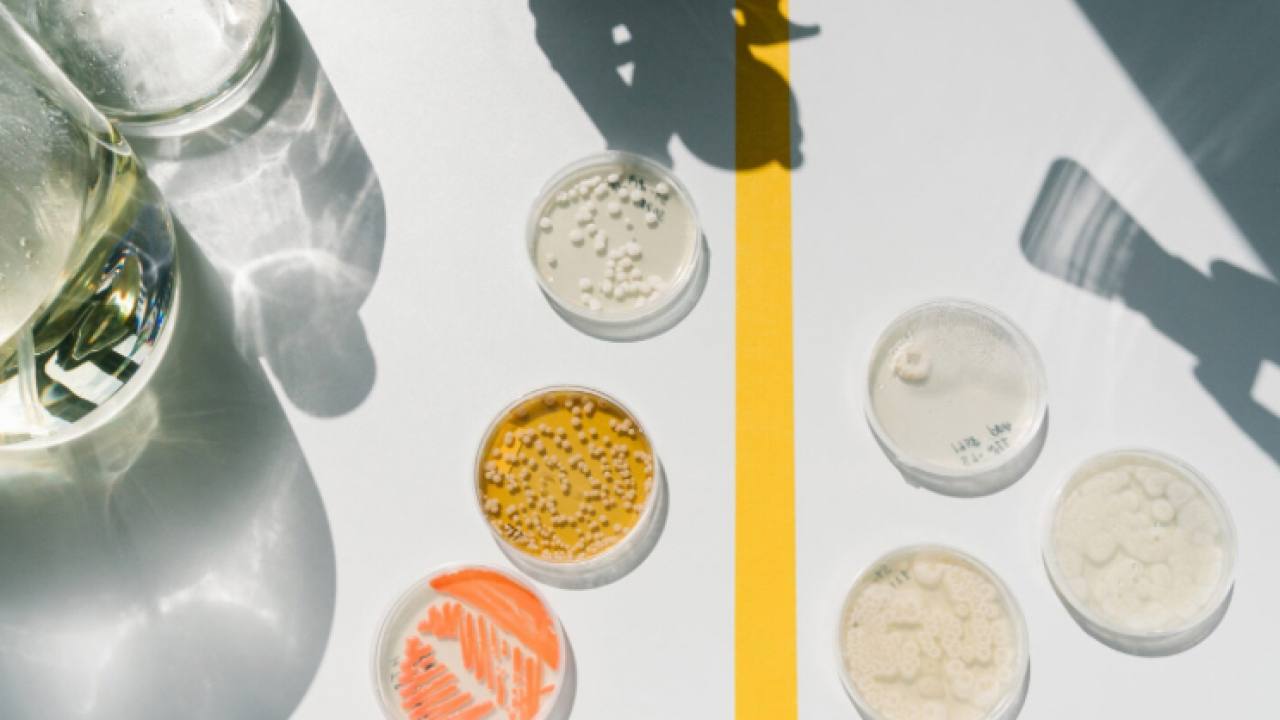
SMEY, AI Destekli Lipid Atlas Platformunu Tanıttı

SMEY, AI Destekli Lipid Atlas Platformunu Tanıttı
SMEY, yapay zeka destekli Lipid Atlas platformunu tanıtarak biyoteknoloji alanında devrim yaratmayı hedefliyor.
SMEY, Fransa ve Almanya merkezli biyoteknoloji şirketi, yenilikçi bir projeye imza atarak Lipid Atlas adlı yapay zeka destekli platformunu duyurdu. Bu platform, biyoteknoloji alanında önemli bir adım olarak değerlendiriliyor.
Lipid Atlas, biyolojik verilerin analiz edilmesine olanak tanıyan bir sistem olarak tasarlandı. Yapay zeka algoritmaları kullanarak, lipidlerin ve diğer biyomoleküllerin etkileşimlerini daha iyi anlamayı amaçlıyor. Bu sayede, araştırmacılara daha hassas ve detaylı veriler sunmayı hedefliyor.
Yenilikçi Yaklaşımlar
SMEY'in CEO'su, bu platformun sadece araştırmalara değil, aynı zamanda endüstriyel uygulamalara da katkı sağlayacağını belirtti. “Lipid Atlas, biyoteknoloji alanında devrim yaratacak bir araç sunuyor. Araştırmacılar, bu platform sayesinde lipidlerin sağlık üzerindeki etkilerini daha iyi analiz edebilecekler” diye ekledi.
Geleceğe Yönelik Vizyon
Fransa ve Almanya'nın güçlerini birleştirdiği bu projeyle, biyoteknoloji sektörü için yeni bir dönemin kapıları aralanıyor. SMEY, Lipid Atlas ile birlikte, sağlık ve yaşam bilimleri alanında daha fazla yeniliğe kapı açmayı hedefliyor.
Kısa süre içerisinde büyük bir ilgi gören Lipid Atlas, biyoteknoloji araştırmalarında önemli bir referans noktası olmayı vaat ediyor. SMEY'in bu cesur girişimi, sektördeki diğer şirketler için de ilham kaynağı olabilir.

Meta, AI Destekli Takı Projesi ile Giyilebilir Teknolojilerdeki Hedeflerini Artırıyor
02 Haziran 2026

Mike Schroepfer, 250 Milyon Dolar Fonla Temiz Enerji İnovasyonunu Destekliyor
02 Haziran 2026

JAAQ, Zihinsel Sağlık Platformunu Geliştirmek İçin 15 Milyon Euro Topladı
01 Haziran 2026

Aizy, Uptmz'ı Satın Alarak Reklam Platformunu Geliştiriyor
30 Mayıs 2026

Helsinki merkezli Avrea, yenilikçi platformunu tanıttı
26 Mayıs 2026

Danimarkalı Perplant, Tarımda Sürdürülebilirliği Destekliyor
25 Mayıs 2026
